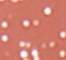

Lipglass
3.1ml
Freshwater pink
Description
A lip gloss.
Enter your gloss boss era with the MAC Cosmetics Lipglass. Offering a sheer veil of shine, this unique gloss is the perfect tool for achieving a high-gloss finish or a subtle, shimmery sheen. With a powerfully pigmented, super shiny formula that harnesses the conditioning power of jojoba oil to soften and condition the lips, this gloss gives you a glass-like shine that lasts whether it’s worn on its own, over lip pencil or lipstick.
Read more
Ingredients
Hydrogenated Polyisobutene, Simmondsia Chinensis (Jojoba) Seed Oil, Octyldodecanol, Copernicia Cerifera (Carnauba) Wax\ Copernicia Cerifera Cera \Cire De Carnauba, Tocopheryl Acetate, Cocos Nucifera (Coconut) Oil, Orbignya Oleifera (Babassu) Seed Oil, Prunus Armeniaca (Apricot) Kernel Oil, Acrylates Copolymer, Alumina, Aluminum Calcium Sodium Silicate, Calcium Aluminum Borosilicate, Calcium Sodium Borosilicate, Silica, Synthetic Fluorphlogopite, Tin Oxide, Polyethylene Terephthalate, Propylene Carbonate, Disteardimonium Hectorite, Ethylhexyl Hydroxystearate, Vanillin, Phenoxyethanol, [+/- Mica, Titanium Dioxide (Ci 77891), Iron Oxides (Ci 77491), Iron Oxides (Ci 77492), Iron Oxides (Ci 77499), Bismuth Oxychloride (Ci 77163), Blue 1 Lake (Ci 42090), Bronze Powder (Ci 77400), Carmine (Ci 75470), Copper Powder (Ci 77400), Red 6 (Ci 15850), Red 6 Lake (Ci 15850), Red 7 Lake (Ci 15850), Red 21 Lake (Ci 45380), Red 28 Lake (Ci 45410), Red 30 Lake (Ci 73360), Red 33 Lake (Ci 17200), Yellow 5 (Ci 19140), Yellow 5 Lake (Ci 19140), Yellow 6 Lake (Ci 15985)]
Directions
- Apply directly to the lips.
Delivery and Returns
Tracked
£3.95
Free on hauls over £30.00
Click and Collect
£3.95
Free on hauls over £30.00
Returns
International
Choose another destination.